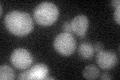
YML021C
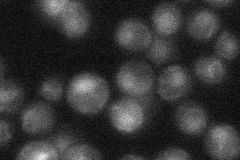
YML021C
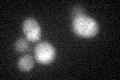
YML021C

View description
Uracil-DNA glycosylase, required for repair of uracil in DNA formed by spontaneous cytosine deamination, not required for strand-specific mismatch repair, cell-cycle regulated, expressed in late G1, localizes to mitochondria and nucleus
Localization:
Intensity:
Fold change:
Significance:
-
C’ GFP library in SD
below threshold17.98 -
N' NOP1pr-GFP in SD

nucleus135.644 -
N' TEF2pr-mCherry in SD

vacuole134.009 -
N' NATIVEpr-GFP in SD
nucleus25.1614 -
N' TEF2pr-VC and Cyto-VN in SD

#N/A0 -
C’ GFP library in SD+DTT
cytosol16.560.92No -
C’ GFP library in SD+H2O2

cytosol17.050.94No -
C’ GFP library in Starvation Media

cytosol22.61.25No -
C’ GFP library on the background of Pup2-DaMP

below threshold -
C’ GFP library on the background of CCT mutant

below threshold17.06850.948891No
